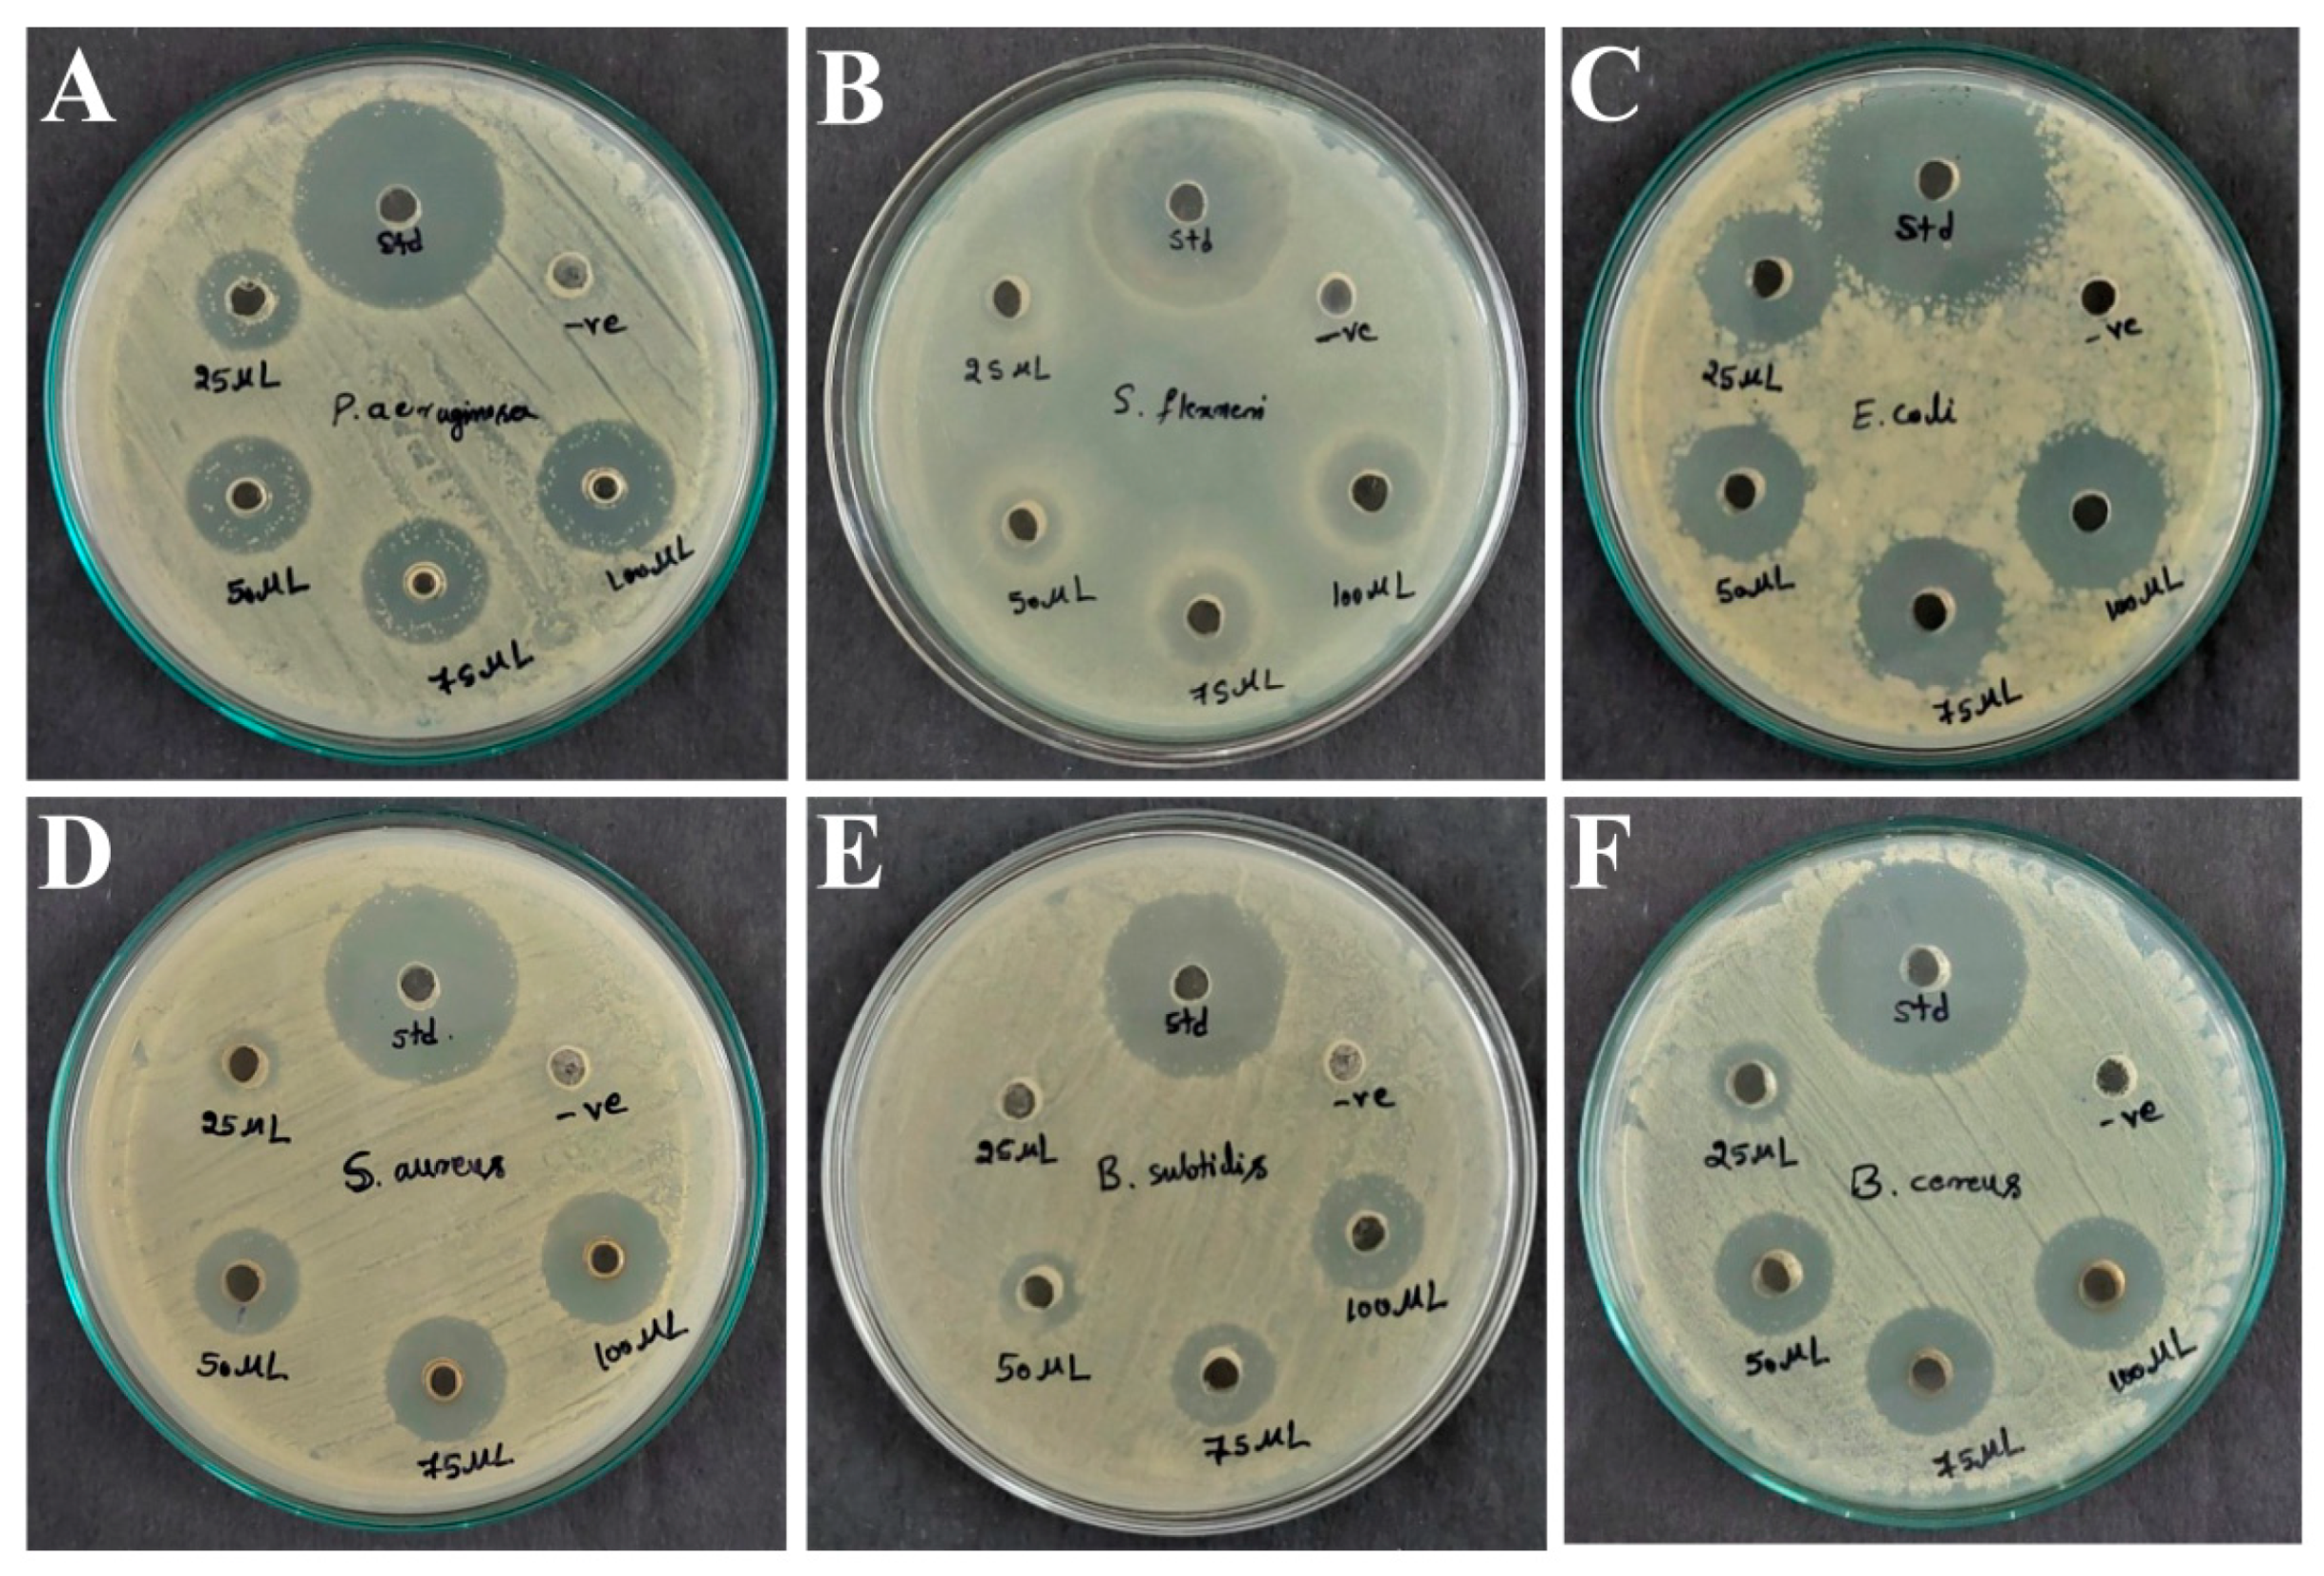
Microorganisms 11 02480 g006 Microorganisms 11 02480 g006

Efficacy of Penicillium limosum Strain AK-7 Derived Bioactive Metabolites on Antimicrobial, Antioxidant, and Anticancer Activity against Human Ovarian Teratocarcinoma (PA-1) Cell Line
Abstract
1. Introduction
2. Materials and Methods
2.1. Collection of Samples, Chemicals, Pathogens, and Cancer Cell Line
2.2. Isolation of Fungi and Primary Screening
2.3. Morphological and Molecular Characterization
2.4. Preparation of Ethyl Acetate Extract of Isolate AK-7
2.5. Fourier Transform Infrared Spectroscopy (FTIR) Analysis
2.6. Gas Chromatography and Mass Spectroscopy (GC-MS) Analysis
2.7. Antibacterial Activity by Well Diffusion Method
2.8. Antifungal Activity by Food Poisoning Method
2.9. Antioxidant Activity
2.10. Anticancer Activity (MTT Assay)
2.11. Apoptosis Assay
2.12. Data Analysis
3. Results
3.1. Isolation of Soil Fungi
3.2. Morphological and Molecular Characterization
3.3. FTIR Analysis
3.4. GC-MS Analysis
3.5. Antibacterial Activity by Well Diffusion Method
3.6. Antifungal Activity by Food Poison Method
3.7. Antioxidant Activity
3.8. Anticancer Activity (MTT Assay)
3.9. Apoptosis Assay
4. Discussion
5. Conclusions
Author Contributions
Funding
Data Availability Statement
Acknowledgments
Conflicts of Interest
References
- Rath, P.; Ranjan, A.; Chauhan, A.; Verma, N.K.; Bhargava, A.; Prasad, R.; Jindal, T. A Critical Review on Role of Available Synthetic Drugs and Phytochemicals in Insulin Resistance Treatment by Targeting PTP1B. Appl. Biochem. Biotechnol. 2022, 194, 4683–4701. [Google Scholar] [CrossRef] [PubMed]
- Zheng, R.; Li, S.; Zhang, X.; Zhao, C. Biological activities of some new secondary metabolites isolated from endophytic fungi: A review study. Int. J. Mol. Sci. 2021, 22, 959. [Google Scholar] [CrossRef] [PubMed]
- Bills, G.F.; Gloer, J.B. Biologically active secondary metabolites from the fungi. Microbiol. Spectr. 2016, 4, 4–6. [Google Scholar] [CrossRef]
- Petit, P.; Lucas, E.M.F.; Abreu, L.M.; Pfenning, L.H.; Takahashi, J.A. Novel antimicrobial secondary metabolites from a Penicillium sp. isolated from Brazilian cerrado soil. Electron. J. Biotechnol. 2009, 12, 8–9. [Google Scholar] [CrossRef]
- Nord, C.; Levenfors, J.J.; Bjerketorp, J.; Sahlberg, C.; Guss, B.; Oberg, B.; Broberg, A. Antibacterial isoquinoline alkaloids from the fungus Penicillium Spathulatum Em19. Molecules 2019, 24, 4616. [Google Scholar] [CrossRef] [PubMed]
- Karpova, N.V.; Yaderets, V.V.; Glagoleva, E.V.; Petrova, K.S.; Ovchinnikov, A.I.; Dzhavakhiya, V.V. Antifungal activity of the dry biomass of Penicillium chrysogenum F-24-28 and is application in combination with azoxystrobin for efficient crop protection. Agriculture 2021, 11, 935. [Google Scholar] [CrossRef]
- Khokhar, I.; Mukhtar, I.; Mushtaq, S. Antifungal effect of Penicillium metabolites against some fungi. Arch. Phytopathol. Plant Prot. 2011, 44, 1347–1351. [Google Scholar] [CrossRef]
- Fernanda, C.L.; Deise, M.T.; Ismael, P.S. Active metabolites produced by Penicillium chrysogenum IFL1 growing on agro-industrial residues. Ann. Microbiol. 2013, 63, 771–778. [Google Scholar]
- Sikandar, A.; Zhang, M.; Wang, Y.; Zhu, X.; Liu, X.; Fan, H.; Xuan, Y.; Chen, L.; Duan, Y. Screening and analysis, antioxidant activity, and biochemical composition of fermentation strain Snef1216 (Penicillium chrysogenum). J. Anal. Method Chem. 2020, 2020, 3073906. [Google Scholar] [CrossRef]
- Le, D.; Chen, K.; Husain, S.; Marathe, A.; Haq, M. Molecular genetics of cancer. Int. J. Human Health Sci. 2018, 2, 199–208. [Google Scholar]
- Bray, F.; Ferlay, J.; Soerjomataram, I.; Siegel, R.L.; Torre, L.A.; Jemal, A. Global cancer statistics 2018: GLOBOCAN estimates of incidence and mortality worldwide for 36 cancers in 185 countries. CA Cancer J. Clin. 2018, 68, 394–424. [Google Scholar] [CrossRef] [PubMed]
- Torre, L.A.; Trabert, B.; Desantis, C.E.; Miller, K.D.; Samini, G.; Runwicz, D.; Gaudt, M.; Jemal, A.; Siegel, R.L. Ovarian cancer statistics. CA Cancer J. Clin. 2018, 68, 284–296. [Google Scholar] [CrossRef] [PubMed]
- Smith, H.O.; Arias, P.H.; Kuo, D.Y.; Howard, T.; Qualls, C.R.; Lee, S.J. GPR30 predicts poor survival for ovarian cancer. Gynecol. Oncol. 2009, 114, 465–471. [Google Scholar] [CrossRef] [PubMed]
- Chandra, A.; Pius, C.; Nabeel, M.; Nair, M.; Vishwanatha, J.K.; Ahmad, S.; Basha, R. Ovarian cancer: Current status and strategies for improving therapeutic outcomes. Cancer Med. 2019, 8, 7018–7031. [Google Scholar] [CrossRef] [PubMed]
- Astuti, P.; Nababan, O.A. Antimicrobial and cytotoxic activities of endophytic fungi isolated from Piper crocatum Ruiz & Pav. Asian Pac. J. Trop. Biomed. 2014, 4, 592–596. [Google Scholar]
- Kharwar, R.N.; Mishra, A.; Gond, S.K.; Stierle, A.; Stierle, D. Anticancer compounds derived from fungal endophytes: Their importance and future challenges. Nat. Prod. Rep. 2011, 28, 1208–1228. [Google Scholar] [CrossRef]
- Gederaas, O.A.; Sogaard, C.; Viset, T.; Bachke, S.; Bruheim, P.; Arum, C.J.; Otterlei, M. Increased anticancer efficacy of intravesical mitomycin c therapy when combined with a PCNA targeting peptide. Transl. Oncol. 2014, 7, 812–823. [Google Scholar] [CrossRef]
- Dasari, S.; Tchounwou, P.B. Cisplatin in cancer therapy: Molecular mechanisms of action. Eur. J. Pharmacol. 2014, 740, 364–378. [Google Scholar] [CrossRef]
- Ashok, A.; Doriya, K.; Rao, J.V.; Qureshi, A.; Tiwari, A.K.; Kumar, D.S. Microbes producing L-Asparaginase free of Glutaminase and Urease isolated from extreme locations of Antarctic Soil and Moss. Sci. Rep. 2019, 9, 1423. [Google Scholar] [CrossRef]
- Elshafei, A.M.; El-Ghonemy, D.H. Screening and media optimization for enhancing L-asparaginase production, an anticancer agent, from different filamentous fungi in solid state fermentation. Biotechnol. J. Int. 2015, 9, 1–15. [Google Scholar] [CrossRef]
- Tijith, K.G.; Devadasan, D.; Jisha, M.S. Chemotaxonomic profiling of Penicillium setosum using high-resolution mass spectrometry (LC-Q-ToF-MS). Heliyon 2019, 5, e02484. [Google Scholar]
- Tapfuma, K.I.; Sebola, T.E.; Okereafor, N.U.; Koopman, J.; Hussan, R.; Makatini, M.M.; Mekuto, L.; Mavumengwana, V. Anticancer activity and metabolite profiling data of Penicillium janthinellum KTMT5. Data Brief 2020, 28, 1049592. [Google Scholar] [CrossRef]
- Chu, Y.C.; Chang, C.H.; Liao, H.R.; Fu, S.L.; Chen, J.J. Anti-Cancer and anti-inflammatory activities of three new chromone derivatives from the marine-derived Penicillium citrinum. Mar. Drugs 2021, 19, 408. [Google Scholar] [CrossRef] [PubMed]
- Jouda, J.B.; Tamokou, J.D.; Mbazoa, C.D.; Sarkar, P.; Bag, P.K.; Wandji, J. Anticancer and antibacterial secondary metabolites from the endophytic fungus Penicillium sp. CAM64 against multi-drug resistant Gram-negative bacteria. Afr. Health Sci. 2016, 16, 734–743. [Google Scholar] [CrossRef] [PubMed]
- Elkhateeb, W.A.; Mettwally, W.S.; Saleh, S.A.; Fayad, W.; Nafady, I.M.; Daba, G.M. Morphomolecular identification, metabolic profile, anticancer, and antioxidant capacities of Penicillium sp. NRC F1 and Penicillium sp. NRC F16 isolated from an Egyptian remote cave. Egypt. Pharm. J. 2022, 21, 57–67. [Google Scholar]
- Canturk, Z.; Artagan, O.; Dikmen, M. Anticancer effects of secondary metabolites of Penicillium chrysogenumvar. Chrysogenum on colon adenocarcinoma cells. Fresenius Environ. Bull. 2016, 25, 6190–6197. [Google Scholar]
- Aziz, N.H.; Zainol, N. Isolation and identification of soil fungi isolates from forest soil for flooded soil recovery. Mater. Sci. Eng. 2018, 342, 012028. [Google Scholar] [CrossRef]
- Hidayat, A.; Turjaman, M.; Faulina, S.A.; Ridwan, F.; Aryanto, N.; Irawadi, T.T.; Iswanto, A.H. Antioxidant and antifungal activity of endophytic fungi associated with agarwood trees. J. Korean Wood Sci. Technol. 2019, 47, 459–471. [Google Scholar] [CrossRef]
- Bhat, M.P.; Nayaka, S.; Kumar, R.S. A swamp forest Streptomyces sp. strain KF15 with broad spectrum antifungal activity against chilli pathogens exhibits anticancer activity on HeLa cells. Arch. Microbiol. 2022, 204, 540. [Google Scholar] [CrossRef]
- Skanda, S.; Vijayakumar, B. Antioxidant and anti-inflammatory metabolites of a soil-derived fungus Aspergillus arcoverdensis SSSIHL-01. Curr. Microbiol. 2021, 78, 1317–1323. [Google Scholar] [CrossRef]
- Nayaka, S.; Chakraborty, B.; Bhat, M.P.; Nagaraja, S.K.; Airodagi, D.; Swamy, P.S.; Rudrappa, M.; Hiremath, H.; Basavarajappa, D.S.; Annanavar, B.K. Biosynthesis, characterization, and in vitro assessment on cytotoxicity of actinomycete-synthesized silver nanoparticles on Allium cepa root tip cells. Beni-Suef Univ. J. Basic Appl. Sci. 2020, 9, 51. [Google Scholar] [CrossRef]
- Sawatdikarn, S. Antifungal activity of crude extracts of some medicinal plants against Fusarium sp., the pathogen of dirty panicle disease in rice. J. Med. Plants Res. 2016, 10, 248–255. [Google Scholar] [CrossRef]
- Basavarajappa, D.S.; Kumar, R.S.; Almansour, A.I.; Chakaraborty, B.; Bhat, M.P.; Nagaraja, K.S.; Hiremath, H.; Perumal, K. Biofunctionalized silver nanoparticles synthesized from Passiflora vitifolia leaf extract and evaluation of its antimicrobial, antioxidant and anticancer activities. Biochem. Eng. J. 2022, 187, 108517. [Google Scholar] [CrossRef]
- Rudrappa, M.; Rudayni, H.A.; Assiri, R.A.; Bepari, A.; Basavarajappa, D.S.; Nagaraja, S.K.; Chakraborty, B.; Swamy, P.S.; Agadi, S.N.; Niazi, S.K. Plumeria alba-Mediated Green Synthesis of Silver Nanoparticles Exhibits Antimicrobial Effect and Anti-Oncogenic Activity against Glioblastoma U118 MG Cancer Cell Line. Nanomaterials. 2022, 12, 493. [Google Scholar] [CrossRef] [PubMed]
- Pangging, M.; Nguyen, T.T.; Lee, H.B. Seven New Records of Penicillium Species Belonging to Section Lanata-Divaricata in Korea. Mycobiology. 2021, 49, 363–375. [Google Scholar] [CrossRef]
- Niazi, S.K.; Basavarajappa, D.S.; Kumaraswamy, S.H.; Bepari, A.; Hiremath, H.; Nagaraja, S.K.; Rudrappa, M.; Hugar, A.; Cordero, M.A.W.; Nayaka, S. GC-MS Based Characterization, Antibacterial, Antifungal and Anti-Oncogenic Activity of Ethyl Acetate Extract of Aspergillus niger Strain AK-6 Isolated from Rhizospheric Soil. Curr. Issues Mol. Biol. 2023, 45, 3733–3756. [Google Scholar] [CrossRef]
- Heyam, G.A.M.; Raghda, A.R. Fermentation extract of Penicillium italicum and Fusarium oxysporum and a statement of its biological effectivenes. Syst. Rev. Pharm. 2021, 12, 1493–1500. [Google Scholar]
- Amir, R.M.; Anjum, F.M.; Khan, M.I.; Khan, M.R.; Pasha, I.; Nadeem, M. Application of fourier transform infrared (FTIR) spectroscopy for the identification of wheat varieties. J. Food Sci. Technol. 2013, 50, 1018–1023. [Google Scholar] [CrossRef] [PubMed]
- Sharma, D.; Pramanik, A.; Agrawal, P.K. Evaluation of bioactive secondary metabolites from endophytic fungus Pestalotiopsisneglecta BAB-5510 isolated from leaves of Cupressus torulosa D. Don. 3 Biotech. 2016, 6, 210. [Google Scholar] [CrossRef] [PubMed]
- Tajick, A.M.; Seid, H.M.K.; Babaeizad, V. Identification of biological secondary metabolites in three Penicillium species, P. goditanum, P. moldavicum, and P. corylophilum. Progress. Biol. Sci. 2014, 4, 53–61. [Google Scholar]
- Grijseels, S.; Christian, J.N.; Ostenfeld, T.L.; Christian, J.F.; Fog, K.N.; John, R.N.F.; Workman, M. Physiological characterization of secondary metabolite producing Penicillium cell factories. Fungal Biol. Biotechnol. 2017, 4, 8. [Google Scholar] [CrossRef] [PubMed]
- Ragavendran, C.; Manigandan, V.; Kamaraj, C.; Balasubramani, G.; Prakash, J.S.; Perumal, P.; Natarajan, D. Larvicidal, histopathological, antibacterial activity of indigenous fungus Penicillium sp. Against Aedes aegypti L. and Culex quinquefasciatus (Say) (Diptera: Culicidae) and its acetylcholinesterase inhibition and toxicity assessment of zebrafish (Danio rerio). Front. Microbiol. 2019, 10, 427. [Google Scholar]
- Nurulita, Y.Y.; Herdiyanti, C.; Khairullinas, N.T.T. Gram positive antibacterial activity of ethyl acetate extracts of Penicillium sp. LBKURCC34’s growth media stimulated by Staphylococcus aureus. J. Phys. Conf. Ser. 2019, 1351, 012043. [Google Scholar] [CrossRef]
- Kumari, N.; Meghani, E.; Mithal, R. Bioactive compounds characterization and antibacterial potentials of actinomycetes isolated from rhizospheric soil. J. Sci. Indus. Res. 2019, 78, 793–798. [Google Scholar]
- Barretto, D.A.; Vootla, S.K. GC-MS analysis of bioactive compounds and antimicrobial activity of Cryptococcus rajasthanensis KY627764 isolated from Bombyx mori gut microflora. Int. J. Adv. Res. 2018, 6, 525–538. [Google Scholar] [CrossRef]
- Garrigues, S.; Gandía, M.; Castillo, L.; Coca, M.; Marx, F.; Marcos, J.F.; Manzanares, P. Three antifungal proteins from Penicillium expansum: Different patterns of production and antifungal activity. Front. Microbiol. 2018, 9, 2370. [Google Scholar] [CrossRef]
- Barekat, S.; Nasirpour, A.; Keramat, J.; Dinari, M.; Meziane-Kaci, M.; Paris, C.; Desobry, S. Phytochemical composition, antimicrobial, anticancer properties, and antioxidant potential of green husk from several walnut varieties (Juglans regia L.). Antioxidants 2023, 12, 52. [Google Scholar] [CrossRef]
- Chandra, P.; Singh, D.A. Antioxidant potential of Penicillium expansum and purification of its functional compound. Asian J. Biotechnol. 2017, 9, 24–34. [Google Scholar] [CrossRef][Green Version]
- Bai, Y.; Yi, P.; Zhang, S.; Hu, J.; Pan, H. Novel antioxidants and α-glycosidase and protein tyrosine phosphatase 1b inhibitors from an endophytic fungus Penicillium brefeldianum F4a. J. Fungi 2021, 7, 913. [Google Scholar] [CrossRef]
- Rahman, M.M.; Islam, M.B.; Biswas, M.; Khurshid, A.H. In vitro antioxidant and free radical scavenging activity of different parts of Tabebuia pallida growing in Bangladesh. BMC Res. Notes 2015, 30, 621. [Google Scholar] [CrossRef]
- Sadiq, A.; Zeb, A.; Ullah, F.; Ahmad, S.; Ayaz, M.; Rashid, U.; Muhammad, N. Chemical characterization, analgesic, antioxidant, and anticholinesterase potentials of essential oils from Isodon rugosus Wall. ex. Benth. Front. Pharmacol. 2018, 9, 623. [Google Scholar] [CrossRef] [PubMed]
- Ashoka, G.B.; Shivanna, M.B. Antibacterial, antioxidant, and anticancer activities of Penicillium citrinum Thom. Endophytic in Jatropha heynei. J. Appl. Pharmacetic. Sci. 2023, 13, 196–207. [Google Scholar] [CrossRef]
- Nagaraja, S.K.; Nayaka, S.; Kumar, R.S. Phytochemical analysis, GC–MS profiling, and in vitro evaluation of biological applications of different solvent extracts of Leonotis nepetifolia (L.) R.Br. flower buds. Appl. Biochem. Biotechnol. 2023, 195, 1197–1215. [Google Scholar] [CrossRef] [PubMed]
- Banakar, P.; Jayaraj, M. GC-MS analysis of bioactive compounds from ethanolic leaf extract of Waltheria indica L.nn and their pharmacological activities. Int. J. Pharm. Sci. Res. 2018, 9, 2005–2010. [Google Scholar]
- Yarazari, S.B.; Jayaraj, M. GC–MS analysis of bioactive compounds of flower extracts of Calycopteris floribunda Lam.: A multi potent medicinal plant. Appl. Biochem. Biotechnol. 2022, 194, 5083–5099. [Google Scholar] [CrossRef]
- Gini, C.K.; Divya, L.M.; Arathi, B.P.; Hari, K.R.S.; Anantha, K.T.H.; Kavya, A.; Jayabhaskaran, C. Extract of Penicillium sclerotiorum an endophytic fungus isolated from Cassia fistula L. induces cell cycle arrest leading to apoptosis through mitochondrial membrane depolarization in human cervical cancer cells. Biomed. Pharmacother. 2018, 105, 1062–1071. [Google Scholar]
- Castro, C.B.; Ramos, A.A.; Prata, S.M.; Malhaqo, F.; Moreira, M.; Gargiulo, D.; Dethoup, T.; Buttachon, S.; Kijjoa, A.; Rocha, E. Marine-derived fungi extracts enhance the cytotoxic activity of Doxorubicin in nonsmall cell lung cancer cells A459. Pharmacogn. Res. 2017, 9, 92–98. [Google Scholar]
- Shashiraj, K.N.; Hugar, A.; Kumar, R.S.; Rudrappa, M.; Bhat, M.P.; Almansour, A.I.; Perumal, K.; Nayaka, S. Exploring the Antimicrobial, Anticancer, and Apoptosis Inducing Ability of Biofabricated Silver Nanoparticles Using Lagerstroemia speciosa Flower Buds against the Human Osteosarcoma (MG-63) Cell Line via Flow Cytometry. Bioengineering 2023, 10, 821. [Google Scholar] [CrossRef]
- Rudrappa, M.; Kumar, R.S.; Nagaraja, S.K.; Hiremath, H.; Gunagambhire, P.V.; Almansour, A.I.; Perumal, K.; Nayaka, S. Myco-Nanofabrication of Silver Nanoparticles by Penicillium brasilianum NP5 and Their Antimicrobial, Photoprotective and Anticancer Effect on MDA-MB-231 Breast Cancer Cell Line. Antibiotics 2023, 12, 567. [Google Scholar] [CrossRef]
- Math, H.H.; Kumar, R.S.; Chakraborty, B.; Almansour, A.I.; Perumal, K.; Kantli, G.B.; Nayaka, S. Antimicrobial Efficacy of 7-Hydroxyflavone Derived from Amycolatopsis sp. HSN-02 and Its Biocontrol Potential on Cercospora Leaf Spot Disease in Tomato Plants. Antibiotics 2023, 12, 1175. [Google Scholar] [CrossRef]
- Venkatachalam, P.; Nadumane, V.K. Modulation of Bax and Bcl-2 genes by secondary metabolites produced by Penicillium rubens JGIPR9 causes the apoptosis of cancer cell lines. Mycology 2019, 12, 69–81. [Google Scholar] [CrossRef] [PubMed]
- Chouni, A.; Pal, A.; Gopal, P.K.; Paul, S. GC-MS Analysis and Screening of Antiproliferative potential of methanolic extract of Garcinia cowa on different cancer cell lines. Pharmacogn. J. 2021, 13, 347–361. [Google Scholar] [CrossRef]
- Sajna, K.V.; Kamat, S.; Jayabaskaran, C. Antiproliferative role of secondary metabolites from Aspergillus unguis AG 1.1 (G) isolated from marine macroalgae Enteromorpha sp. by inducing intracellular ROS production and mitochondrial membrane potential loss leading to apoptosis. Front. Mar. Sci. 2020, 7, 543523. [Google Scholar] [CrossRef]

| Fungal Isolates | Pathogens | |||||
|---|---|---|---|---|---|---|
| P. aeruginosa | S. flexneri | E. coli | S. aureus | B. subtilis | B. cereus | |
| AK-1 | - | - | - | - | + | - |
| AK-2 | - | - | - | + | - | - |
| AK-3 | - | + | - | + | + | + |
| AK-4 | + | - | - | + | + | + |
| AK-5 | - | - | - | + | - | - |
| AK-6 | - | - | - | - | - | + |
| AK-7 | +++ | +++ | +++ | +++ | +++ | +++ |
| AK-8 | - | - | + | + | + | + |
| AK-9 | - | - | - | - | + | - |
| AK-10 | + | + | - | - | + | + |
| AK-11 | ++ | + | ++ | ++ | +++ | ++ |
| AK-12 | - | - | - | - | + | - |
| AK-13 | - | - | + | + | + | + |
| AK-14 | + | ++ | +++ | ++ | ++ | ++ |
| AK-15 | - | + | + | - | + | + |
| AK-16 | - | - | - | - | + | - |
| AK-17 | ++ | +++ | ++ | ++ | +++ | ++ |
| Peak No. | Retention Time | Area % | Compound Name | Molecular Formula | Molecular Weight |
|---|---|---|---|---|---|
| 1 | 37.514 | 1.16 | Nonadecane | C19H40 | 268.5 |
| 2 | 35.068 | 9.28 | Tricosane | C23H48 | 324.6 |
| 3 | 36.713 | 15.67 | Eicosane | C20H42 | 282.5 |
| 4 | 38.297 | 20.34 | Heneicosane | C21H44 | 296.6 |
| 5 | 39.816 | 21.03 | Celidoniol, Deoxy- | C29H60 | 408.79 |
| 6 | 41.276 | 18.30 | Tetratetracontane | C44H90 | 619.2 |
| 7 | 42.680 | 12.51 | Hexatriacontane | C36H74 | 507.0 |
| 8 | 47.200 | 1.71 | Pentatriacontane | C35H72 | 492.9 |
Disclaimer/Publisher’s Note: The statements, opinions and data contained in all publications are solely those of the individual author(s) and contributor(s) and not of MDPI and/or the editor(s). MDPI and/or the editor(s) disclaim responsibility for any injury to people or property resulting from any ideas, methods, instructions or products referred to in the content. |
© 2023 by the authors. Licensee MDPI, Basel, Switzerland. This article is an open access article distributed under the terms and conditions of the Creative Commons Attribution (CC BY) license (https://creativecommons.org/licenses/by/4.0/).
Share and Cite
Basavarajappa, D.S.; Niazi, S.K.; Bepari, A.; Assiri, R.A.; Hussain, S.A.; Muzaheed; Nayaka, S.; Hiremath, H.; Rudrappa, M.; Chakraborty, B.; et al. Efficacy of Penicillium limosum Strain AK-7 Derived Bioactive Metabolites on Antimicrobial, Antioxidant, and Anticancer Activity against Human Ovarian Teratocarcinoma (PA-1) Cell Line. Microorganisms 2023, 11, 2480. https://doi.org/10.3390/microorganisms11102480
Basavarajappa DS, Niazi SK, Bepari A, Assiri RA, Hussain SA, Muzaheed, Nayaka S, Hiremath H, Rudrappa M, Chakraborty B, et al. Efficacy of Penicillium limosum Strain AK-7 Derived Bioactive Metabolites on Antimicrobial, Antioxidant, and Anticancer Activity against Human Ovarian Teratocarcinoma (PA-1) Cell Line. Microorganisms. 2023; 11(10):2480. https://doi.org/10.3390/microorganisms11102480
Chicago/Turabian StyleBasavarajappa, Dhanyakumara Shivapoojar, Shaik Kalimulla Niazi, Asmatanzeem Bepari, Rasha Assad Assiri, Syed Arif Hussain, Muzaheed, Sreenivasa Nayaka, Halaswamy Hiremath, Muthuraj Rudrappa, Bidhayak Chakraborty, and et al. 2023. "Efficacy of Penicillium limosum Strain AK-7 Derived Bioactive Metabolites on Antimicrobial, Antioxidant, and Anticancer Activity against Human Ovarian Teratocarcinoma (PA-1) Cell Line" Microorganisms 11, no. 10: 2480. https://doi.org/10.3390/microorganisms11102480
APA StyleBasavarajappa, D. S., Niazi, S. K., Bepari, A., Assiri, R. A., Hussain, S. A., Muzaheed, Nayaka, S., Hiremath, H., Rudrappa, M., Chakraborty, B., & Hugar, A. (2023). Efficacy of Penicillium limosum Strain AK-7 Derived Bioactive Metabolites on Antimicrobial, Antioxidant, and Anticancer Activity against Human Ovarian Teratocarcinoma (PA-1) Cell Line. Microorganisms, 11(10), 2480. https://doi.org/10.3390/microorganisms11102480

